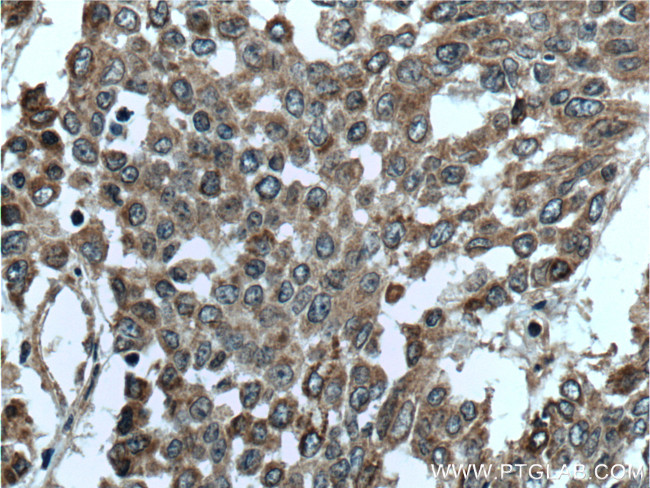
DALRD3 Antibody in Immunohistochemistry (Paraffin) (IHC (P))
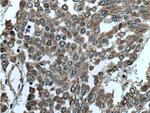
DALRD3 Antibody in Immunohistochemistry (Paraffin) (IHC (P))

Search
Proteintech
DALRD3 Polyclonal Antibody
{{$productOrderCtrl.translations['antibody.pdp.commerceCard.promotion.promotions']}}
{{$productOrderCtrl.translations['antibody.pdp.commerceCard.promotion.viewpromo']}}
{{$productOrderCtrl.translations['antibody.pdp.commerceCard.promotion.promocode']}}: {{promo.promoCode}} {{promo.promoTitle}} {{promo.promoDescription}}. {{$productOrderCtrl.translations['antibody.pdp.commerceCard.promotion.learnmore']}}
产品信息
26294-1-AP
种属反应
宿主/亚型
分类
类型
抗原
偶联物
形式
浓度
规格
纯化类型
保存液
内含物
保存条件
运输条件
产品详细信息
Immunogen sequence: MATRRLGVG ETLGALNAAL GPGGPVWIKE TRTRHLRSRD FLAPHRALQA RFDDGQVPEH LLHALACLQG PGVAPVLRCA PTPAGLSLQL QRSAVFERVL SAVAAYATPA SPASLGQRVL LHCPALRSSP CALRLSQLRT VLVADHLARA LRAHGVCVRL VPAVRDPHML TFLQQLRVDW PAASERASSH TLRSHALEEL TSANDGRTLS PGILGRLCLK ELVEEQGRTA GYDPNLDNCL VTEDLLSVLA ELQEALWHWP EDSHPGLAGA SDTGTGGCLV VHVVSCEEEF QQQKLDLLWQ KLVDKAPLRQ KHLICGPVKV AGAPGTLMTA PEYYEFRHTQ VCKASALKHG (1-349 aa encoded by BC047683)
靶标信息
The exact function of this gene is not known. It encodes a protein with a DALR anticodon binding domain similar to that of class Ia aminoacyl tRNA synthetases. This gene is located in a cluster of genes (with a complex sense-anti-sense genome architecture) on chromosome 3, and contains two micro RNA (miRNA) precursors (mir-425 and mir-191) in one of its introns. Preferential expression of this gene (the miRNAs and other genes in the cluster) in testis suggests a role of this gene in spermatogenesis.
仅用于科研。不用于诊断过程。未经明确授权不得转售。
生物信息学
蛋白别名: DALR anticodon-binding domain-containing protein 3; unnamed protein product
基因别名: DALRD3; DEE86; EIEE86
UniProt ID: (Human) Q5D0E6
Entrez Gene ID: (Human) 55152